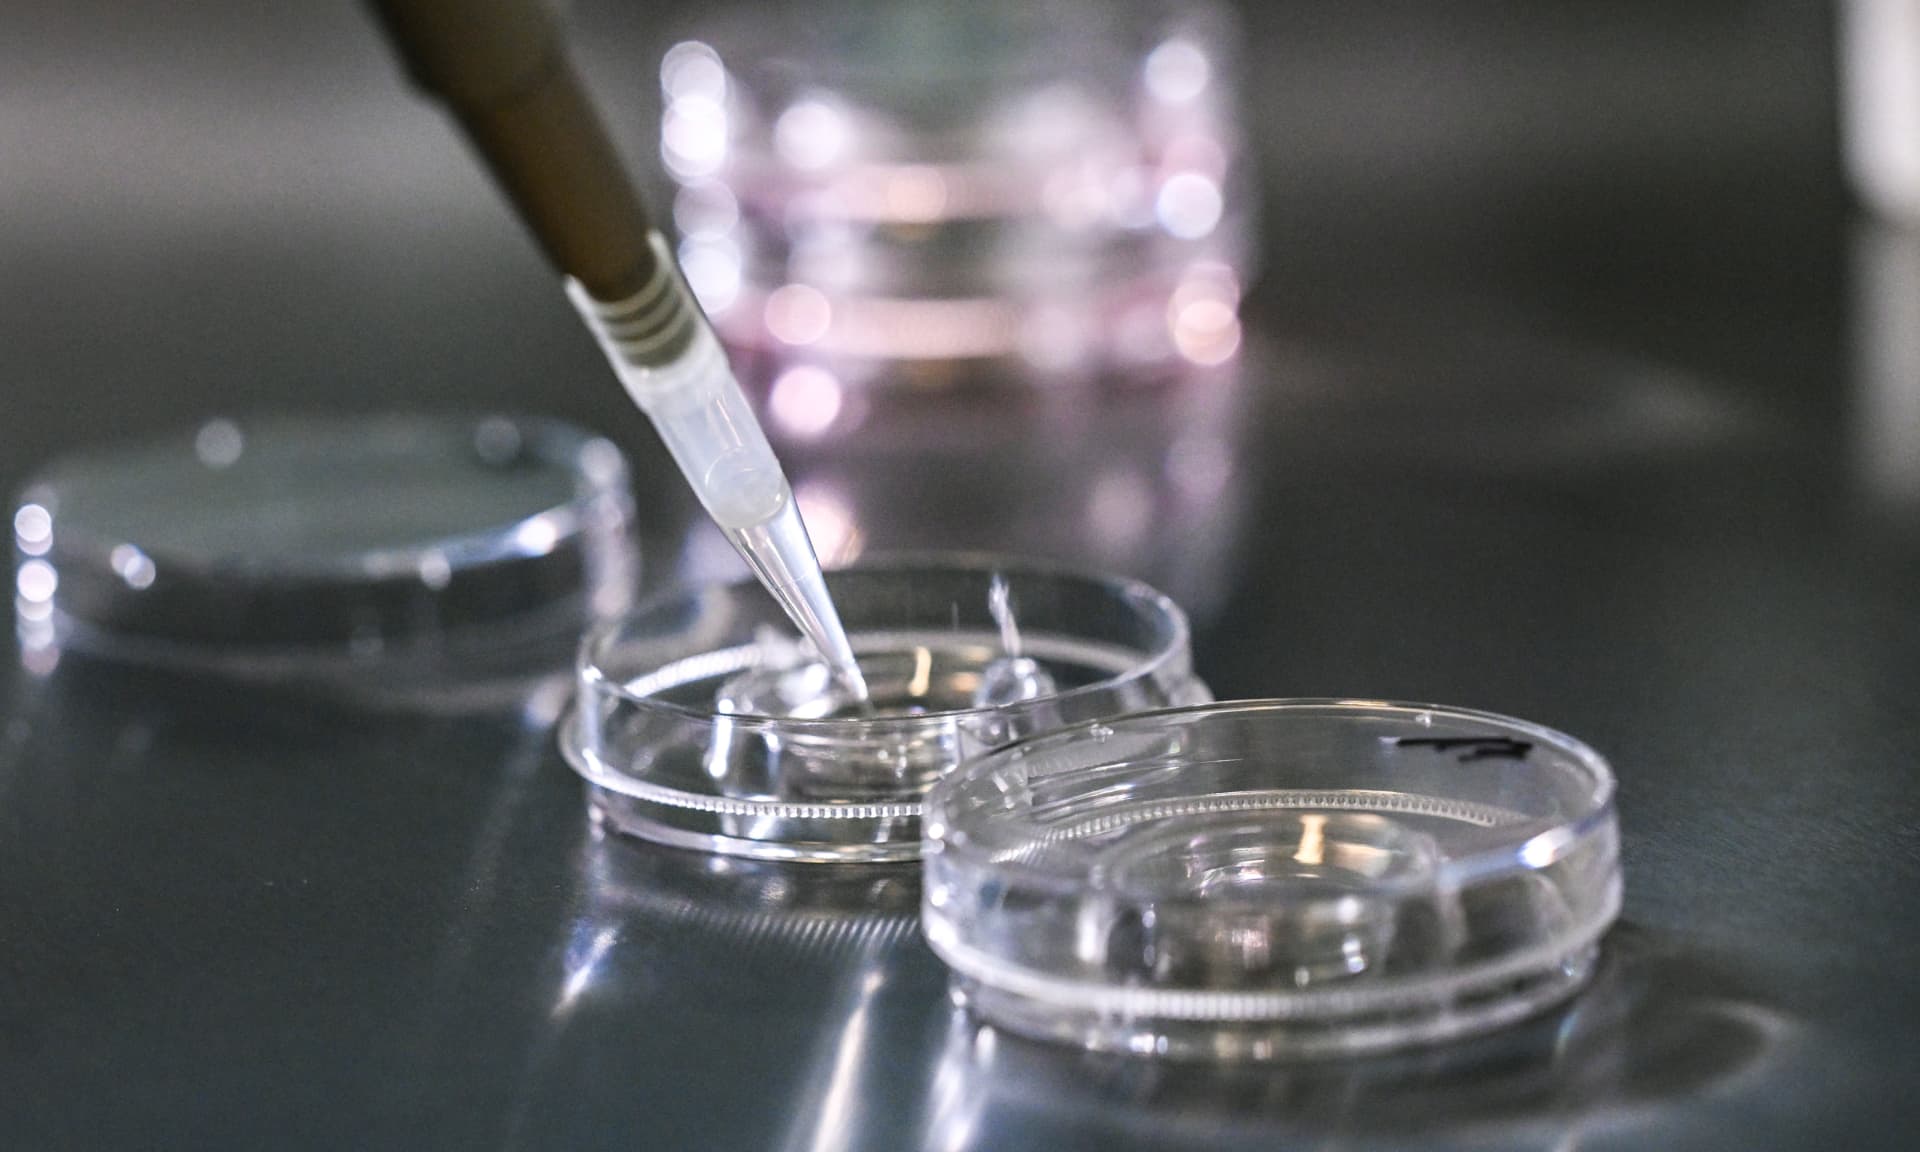
Embryos in a lab

top story
The Legal Route
The Story
Alabama’s lawmakers are scrambling to protect in vitro fertilization (IVF).
Tell me more.
Earlier this month, Alabama’s Supreme Court ruled that frozen embryos are children, raising questions over the liability of destroying them. It’s caused legal uncertainty as IVF usually creates more than one embryo, and it’s not uncommon for them to be discarded if there are abnormalities or if patients don’t want to use them. To avoid potential prosecution, at least three IVF clinics in the state paused operations. In response, Alabama lawmakers introduced legislation to try to clarify the law and dispel fears.
What are they proposing?
Last week, an Alabama House Democrat intro’d a bill that asserts a fertilized egg or embryo outside of a uterus is not considered an unborn child under state law. Meanwhile, two Republican measures proposed in the state Senate would each grant legal immunity to clinics providing IVF treatment. But they fall short of changing the state's definition of an embryo. The GOP legislation could be more likely to pass, given that Republicans have a supermajority in the state. One of the GOP bill's sponsors says he expects a measure to reach Republican Gov. Kay Ivey's desk in a few weeks.
What else is being done?
There's some action at the federal level. Today, Sen. Tammy Duckworth (D-IL) plans to bring up a vote on legislation to protect access to IVF nationally. But while Democrats have been vocal about protecting IVF, Republicans have been harder to pin down. Already, some GOP senators have reportedly said they plan to block Duckworth's bill. In the House, some GOP members say they fully support a family’s right to use IVF. But last year, 125 House Republicans signed on to the Life at Conception Act which — as its name implies — defines life at conception. The bill would essentially ban all abortions in the US and leave IVF treatment in jeopardy. Now, these lawmakers are being asked to clarify their position given the widespread reaction to the Alabama ruling.
theSkimm
When Roe v. Wade was overturned, there were fears that IVF would be next on the list to be restricted. A year and a half later, that's proving to be true. Now, lawmakers have to decide where the line ends and how to appeal to voters on this key election issue.
and also...this
Where voters made themselves heard...
Michigan. Yesterday, President Biden won the state's Democratic presidential primary after facing backlash over his handling of the Israel-Hamas war. About 15% of voters cast a ballot for “uncommitted,” instead of picking Biden. The results depict the growing criticism Biden has faced from progressives, as well as from many Arab and Muslim Americans, for not demanding a permanent cease-fire. Ahead of the contest, state and local leaders, including Rep. Rashida Tlaib (D-MI), called on voters to cast their ballots as “uncommitted” to send Biden the message to “change course on Gaza.” Michigan — home to one of the largest Arab and Muslim American communities in the US — is considered a litmus test for how the Biden admin’s handling of the conflict could play out in the November election.
…Oh and speaking of the election, a Trump-Biden rematch is looking more likely. Former President Trump easily beat former UN ambassador Nikki Haley in Michigan’s Republican presidential primary last night, securing his sixth straight win.
What’s got the Ozempic team on alert…
This new weight loss drug. A small biotech company called Viking Therapeutics put itself on the map yesterday after showing promising results in a mid-stage trial. Its drug appears to be effective and not cause major side effects. The company still needs to replicate the results in its late-stage trials before the FDA stamps its approval, but that didn’t curb Wall Street’s hunger. Just remember to talk to your doc before jumping on the trend.
What’s staying out of Tesla’s lane…
Apple. Yesterday, multiple reports said the tech giant scrapped its secret plans — dubbed Project Titan — for a self-driving electric car. Apple had reportedly been working on the project for a decade but has now shifted gears to focus on AI.
Who wants his side to be heard...
A man claiming to be the ex in “Who TF Did I Marry?”
Who allegedly threw a punch…
What’s adding a new member to its Fab Five...
theskimm: here's what's next
theSkimm helps you tackle your to-do lists, whether you're refinancing your loans or choosing a daycare for the first time. We talk to experts and real women to empower you to make decisions faster and with more confidence. Check out our guides to get started.
PS: Your feedback makes a big impact. Let us know what you like, what could be improved, and most importantly, if we helped you get sh*t done. Share your thoughts.
Photos by Picture Alliance via Getty Images, Brand Partners
Design by theSkimm
*PS: This is a sponsored post.
Live Smarter
Sign up for the Daily Skimm email newsletter. Delivered to your inbox every morning and prepares you for your day in minutes.